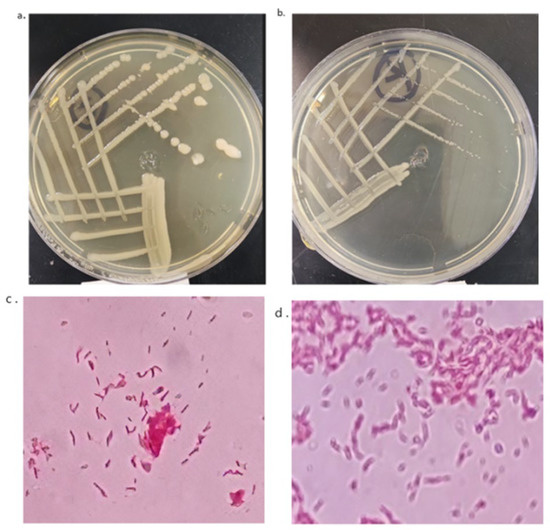

Abstract
Plastic pollution is one of the most serious environmental issues, causing severe environmental damage. It is of vital importance to find an efficient and eco-friendly approach to biodegrading plastics. The aim of this study was to isolate and characterize different bacterial isolates from water samples in the Al-Ahsa region of Saudi Arabia. The ability to degrade low-density polyethylene (LDPE) plastic was evaluated using multiple approaches, including changes in the media pH values, weight loss, Fourier transform infrared (FTIR), and gas chromatography–mass spectrometry (GC–MS). The water samples were collected from plastic-contaminated sites in Al-Ahsa, and bacterial isolates were obtained using a mineral nutrient medium (MNM) enriched with LDPE as the only carbon and energy source. Two bacterial isolates (APCK5 and APCZ14) were obtained and they showed potential LDPE degradation, as evidenced by changes in media pH (from 7.0 ± 0.03 to 6.17 ± 0.05 and 6.22 ± 0.03), LDPE weight reduction (8.1 ± 0.63% and 18.85 ± 0.96%, respectively), and FTIR and GC–MS analyses. Based on 16S rRNA gene similarities, APCZ14 and APCK5 were determined to be most closely related to the genus Brucella. APCZ14 exhibited a 99.48% homology with Brucella cytisi, whereas APCK5 showed a 99.33% similarity level to Brucella tritici. In conclusion, both bacterial strains had high efficiency in plastic biodegradation and could be developed for wide use as an eco-friendly method to remove or reduce plastic pollutants from the environment.
1. Introduction
Plastics synthesized as basic polymers aggregated into usable forms, which are shaped and released into the market, have gained popularity due to their low cost, ease of molding, bio-inactivity, and hydrophobic nature [1]. Plastic is widely used in different applications, including medical, industrial, agricultural, food packaging, car manufacturing, building, and construction [2]. Plastic production in Asia alone reached 45%; joined with that in the United States and Europe, this accounts for 85% of plastic production in the world [3]. Saudi Arabia is one of the world’s largest producers of plastic, producing over six million tons per year, and plastic trash accounts for about 15% of the country’s total municipal waste [4]. In 2019, Saudi Arabia’s plastics import rate reached 10.2% [5]. On the other hand, Saudi Arabia is one of the most important packaging industry markets in the Middle East. In 2020, the Saudi Arabia plastic packaging market reached USD 5.82 billion, and by 2026, it is expected to reach USD 7.92 billion [6,7]. The global amount of plastic is increasing by 12% per year, with 0.15 billion tons of synthetic polymers developed each year; thus, the plastic accumulation rate in the environment is estimated to be 25 million tons per year [8].
About 70% of Middle East ethylene is utilized for polyethylene manufacturing, while 91% is propylene for polypropylene [9]. Polyethylene is a common polymer that accounts for at least 64% of all synthetic plastics manufactured [10]. Polyethylene is a thermoplastic polymer that is made from ethylene monomers, which are composed of carbon and hydrogen. The most common types of polyethylene are HDPE (High-density polyethylene), LLDPE (Linear low-density polyethylene) and LDPE (Low-density polyethylene) [11]. Polyethylene waste accumulation in the environment causes blockages in fishes, mammals, and birds, endangering a large number of species. LDPE plastic waste is contributing to microplastic pollution, causing huge environmental threats without getting adequately managed at the end level of the value chain and seriously polluting the oceans [4,12]. Microplastics are accumulating because of the surface weathering and degradation of plastic trash, and their extremely small size allows for rapid ingestion by and interaction with marine life [12,13,14]. In addition, open, uncontrolled burning and landfilling are used to dispose of the plastics, leading to the release of toxins into the air and causing a variety of health issues. Furthermore, burning plastic releases hazardous compounds that cause immunological problems and lung illnesses, as well as being classified as potential human carcinogens [15].
Microbes are naturally performing degradation on complex organic matters, converting them into simpler organic substances and gaining nutrients during this process. Plastic waste has energy and carbon sources that help microbes in their survival. Plastics can degrade in aerobic or anaerobic conditions, and they can be used as a major natural cleanup at locations where toxic waste is disposed of [16,17]. Additionally, biodegradation of polymers is defined as any change in polymer characteristics, such as molecular weight, mechanical strength, and surface features, or, in other words, the breakdown of material into pieces through microbial digestion into a simpler form via biochemical transformation [18]. Microorganisms that can break down these polymers and minimize their potentially hazardous effects attract global interest. It is well documented that diverse microbial groups, such as bacteria, actinomycetes, and fungi, exhibit the ability to degrade plastic [4,19]. Over 90 species of bacteria, fungi, and actinomycetes have the potential to break down plastic [20]. About 436 species of bacteria have been recorded to break down plastics, including various species within the genera Oceanimonas, Vibrio, Paenibacillus, Shewanella, Rheinheimera, and Bacillus [21]. Bacterial species involved in the biodegradation of plastic contaminants frequently inhabit landfills and plastic waste disposal sites [22]. Examples are Pseudomonas alcaligenes, Bacillus cereus [23], Alcanivorax sp. [24], Bacillus licheniformis, and Sb2 as Achromobacter xylosoxidans [25]. Flavobacteriaceae, Rhodobacteraceae, and Vibrionaceae are primary plastic degraders [26]. Furthermore, it has recently been reported that a consortium of three yeast species (Sterigmatomyces halophilus, Meyerozyma guilliermondii, and Meyerozyma caribbica) showed a substantial ability for degradation of LDPE [27]. The extent of plastic degradation via microorganisms varies from species to species. It has been reported that Bacillus cereus and Brevibacillus borstelensis exhibited degradation activity at 35.72% and 20.28%, respectively [28]. Furthermore, Bacillus sp., isolated from soil samples collected in Jayawijaya Mountain, Papua, Indonesia, was capable of degrading synthetic polyethylene terephthalate plastic films up to 4.77 b/b for four weeks. [22].
Microorganisms secrete enzymes that start plastic degradation, including multicopper oxidase, manganese peroxidase, laccase, alkane hydroxylase, alkane monooxygenase, and the ligninolytic enzyme [29]. Microorganisms can depolymerize these polymers by secreting enzymes called intracellular and extracellular depolymerases. These exoenzymes depolymerize polymers into monomers, which can then enter cell walls and be used as energy sources [30,31]. However, pretreatment of the polymer, which facilitates the oxidation to produce a carbonyl group C=O, can reduce the time required to biodegrade LDPE and can help facilitate the first step in polymer biodegradation [32].
There have been no intensive studies conducted in the Kingdom of Saudi Arabia’s Eastern Province to describe and characterize the microorganisms capable of removing plastic contaminants from the environment. It has been reported that pyrene- and phenanthrene-degrading bacteria (Pseudomonas aeruginosa, P. citronellolis, Ochrobactrum intermedium, and Cupriavidus taiwanensis) were isolated from the Eastern Province, Saudi Arabia [33]. Furthermore, in the Al-Ahsa region, there are several industrial, medical, and domestic areas with plastic contamination, reflecting the potential risk to human health and existing organisms. Therefore, there is a desperate need to restore the environment to its original, healthy state. That is why we intend to look into the issue of plastic degradation and the bacterial species involved in the mechanism. This study aimed to isolate and identify bacterial species that have the potential to degrade low-density polyethylene (LDPE) from soil samples collected from a plastic dumping ground. The extent of degradation was analyzed, and morphological changes in the plastic powder were determined using weight loss and FTIR. The molecular identification of the isolated bacterial strains using 16S RNA gene analysis was also determined.
2. Materials and Methods
2.1. Sample Collection, Enrichment, and Isolation of LDPE-Degrading Bacteria
The Eastern Region is home to many industrial activities where plastic is manufactured and disposed of. Water samples (with depths of about 10 cm) were collected in sterilized glass containers from Al-Ahsa plastic products company (25.619483, 49.54788) and transferred immediately to the laboratory at King Faisal University in Al-Ahsa. The temperature of the samples was measured and recorded on site, and the pH of the samples was measured and recorded in the lab [34]. One ml of each sample was mixed with 50 mL of sterile normal saline solution (0.85% NaCl solution) and kept in the incubator for 3 h at 37 °C with shaking to fractionate the bacterial cells away from the sample particles, according to [34]. After 3 h, 1% of the prepared inoculum and 2 g of low-density polyethylene powder as the sole carbon source were weighed, disinfected in 70% ethanol, dried for 20 min in an oven (60 °C), and were added to 200 mL of each synthetic medium (SM) with the following compositions: 0.1% (NH4)2SO4, 0.1% NaNO3, 0.1% K2HPO4, 0.1% KCl, 0.02% MgSO4, and 0.001% yeast extract in one liter of distilled water [34]. Negative control with no added inoculum was used. The flasks were incubated at 30 °C for 180 days at 150 rpm of shaking. After the incubation period, 200 μL of each artificial medium was spread on Nutrient Agar (NA) and incubated for 48 h at 30 °C. Two different bacterial isolates were obtained and designated as K and Z. The isolates were preserved in NB with 20% glycerol and stored at −20 °C. For routine use, the isolates were streaked on NA slants and stored at 8 °C. These strains were subcultured on a regular basis every 3–4 weeks.
2.2. Characterization and Identification of Bacterial Isolates
The morphological characteristics, including the colony shape, color, size, and elevation, were determined for the two bacterial isolates after growth on NA plates at 30 °C for 24 h. The Gram reaction was also determined according to the method mentioned earlier [35].
Genomic DNA was extracted from single colonies of the two bacterial isolates using the InstaGene Matrix (Bio-Rad, USA) as instructed by the manufacturer. Cells were boiled at 95 °C for 5 min, followed by centrifugation for 10 min at 10,000 rpm to precipitate the cells [36]. The supernatant was used as the DNA template for the PCR reaction. The PCR reaction was performed in a 25 μL volume, consisting of 12.5 μL PCR Master Kit (2×), 1 μL of each primer, and 1μL of the DNA template, except for the negative control. Each isolate’s 16S rRNA gene was amplified using the universal primers, forward primer (8-F) 5’-AGAGTTTGATCCTGGCTCAG-3’, and reverse primer(1492R) 5’-GGTTACCTTGTTACGACTT-3’ [37]. In 30 cycles of amplification, the following primary PCR steps were performed: initial denaturation at 94 °C for 5 min, followed by denaturation at 94 °C for 45 s, annealing at 55 °C for 60 s, extension at 72 °C for 60 s, and final extension at 72 °C for 10 min. The PCR product was resolved by electrophoresis in a 1% agarose gel with 100 mL of 1x TAE buffer after amplification. Because ethidium bromide (EtBr) attaches to DNA and may be seen on a gel documentation system, EtBr was injected at a concentration of about 2–4 L. [38]. For the purpose of estimating the predicted size of the PCR results, a 1 kb DNA ladder was utilized as a marker. A DNA purification kit was used to clean the PCR products (Qiagen).
The 16S rRNA gene for bacterial isolates was sequenced on an automated DNA sequencing machine made by Applied Biosystems (model 3730XL), then compared with those in the GenBank database using the BLAST algorithm (National Center for Biotechnology Information, Bethesda, MD, USA). Phylogenetic trees were constructed using the Mega7 program, using the neighbor-joining method based on the Tamura–Nei model [37,39].
2.3. Biodegradation of LDPE
2.3.1. Determination of pH Values of the Media and Weight Loss for LDPE Plastic Powder
The capacity of pure APCK5 and APCZ14 to break down LDPE plastic was studied using synthetic medium containing LDPE as the sole source of energy and carbon. The pH value was estimated at the beginning and at the end of the experiment according to [40].
The LDPE powder that was added to the SM was removed after the incubation period using filtration, then rinsed with sterile distilled water and left to dry for three days [41,42]. The weight loss was recorded according to the method mentioned earlier [43]. The percentage weight loss was determined using the formula:
2.3.2. FTIR Analysis
The surface structure of the LDPE powder was examined using the Equinox 55 FTIR spectrometer, according to [44]. For every incubated LDPE powder after 180 days, a spectrum was taken from a range of 400 to 4000 wavelengths at a resolution of 2 cm−1 over 32 scans and compared with the negative control.
2.3.3. Gas Chromatographic Analysis (GC–MS)
The GC–MS technique was conducted to analyze and identify the extent of degradation of LDPE polymer by the bacterial isolates. Interactions can be carried out under normal growth conditions, as well as at high temperatures to compare the extent of LDPE degradation.
After six months, the PE powder was removed, and SM media were centrifuged at 8000 rpm for 5 min at room temperature, then filtered to remove the cell debris. The PE degradation products were obtained using diethyl ether as a solvent. Ten milliliters of each filtrated SM was dissolved in 10 mL of diethyl ether, kept overnight, and then separated using a separating funnel [45]. The obtained organic extract was analyzed in a Shimadzu GC–MS model QP2010 SE equipped with an Rxi-5 Sil MS capillary column (30 mm length, 0.25 mm ID, and 0.25 µm film thickness) [46]. The mobile phase was high-purity helium (99.99% pure) at a flow rate of 1 mL/min. The 1 µL sample was injected into the split/splitless inlet in splitless mode at 220 °C. The temperature programming for the GC–MS method analysis starts with the oven temperature at 50 °C for 5 min, then increases by 7 °C/min to 240 °C for 15 min. The temperature of the interface was 250 °C and the ion source 220 °C. The range of scan mode used for data acquisition was 50–550 amu. The relative amount of each constituent was calculated by measuring the corresponding peak area and represented as a percentage of the sum of the areas of all peaks [47].
2.4. Statistical Analysis
The mean of three replicates and the standard deviation are used to represent the data (SD). The data were subjected to ANOVA, and mean comparisons were performed in Microsoft Excel using a post hoc test. Mean differences were considered statistically significant when the p value was less than 0.05.
3. Results
This study aimed to isolate and characterize bacterial species that have the potential to degrade LDPE plastic from Al-Ahsa in Saudi Arabia. The enrichment method with LDPE as the sole source of carbon and energy using a synthetic medium resulted in the purification of two bacteria out of 50 isolated from a water sample at Al-Ahsa Plastic Products Company, which were selected for subsequent characterization and designated APCK5 and APCZ14 (Table 1). The physical parameters were 7.72 ± 0.05 for the pH, and the temperature was 33 °C (Table 1).

Table 1.
Site of sampling, temperature, and pH values from which bacterial isolates were obtained.
3.1. Identification of LDPE-Degrading Bacteria
Morphological Characterization
Two different bacterial isolates (APCK5 and APCZ14) were obtained out of the enrichment technique found to be efficient in degrading LDPE. The morphological characteristics of APCK5 and APCZ14 are presented in Figure 1 and Table 2. Both isolates formed circular-shaped colonies with entire margins and convex elevation. APCK5 formed wide (5–7 mm diameter), creamy white colonies, while APCZ14 were 3–4 mm in diameter and white in color (Table 2).
Figure 1.
Bacterial colonies of APCZ14: (a) APCK5, (b) on nutrient agar plates, (c) APCZ14 under microscope, and (d) APCK5 under microscope.

Table 2.
Morphological characteristics and pairwise similarity (%) of APCZ14 and APCK5.
The evolutionary history was inferred using the neighbor-joining method [48]. The optimal tree is shown. The evolutionary distances were computed using the Maximum Composite Likelihood method [49] and are in the units of the number of base substitutions per site. This analysis involved 18 nucleotide sequences. Codon positions included were 1st + 2nd + 3rd + Noncoding. All ambiguous positions were removed for each sequence pair (pairwise deletion option). There were a total of 1481 positions in the final dataset. Evolutionary analyses were conducted in MEGA11 [50].
Based on 16S rRNA gene similarities, APCZ14 and APCK5 were determined to be most closely related to the genus Brucella.
APCZ14 exhibited a 99.48% homology with Brucella cytisi ESC1 (accession number AY776289), whereas APCK5 showed a 99.33% similarity level to Brucella tritici SCII24 AJ242584 (Table 2 and Figure 2).

Figure 2.
Evolutionary relationships of taxa.
3.2. Detection of LDPE Biodegradation Assay
3.2.1. Measurement of pH Values of the Media
The variations in the pH value of the SM before and after incubation with LDPE were determined using a pH meter. As can be seen in Table 2, the pH value decreased from 7.0 ± 0.03 to 6.17 ± 0.05 and 6.22 ± 0.03 for APCK5 and APCZ14, respectively, after 180 days of incubation (Table 3). Nonetheless, the untreated control media did not show any change in the pH value after the incubation period.

Table 3.
Changes in pH values of the media and reduction percentage in LDPE weight.
3.2.2. Weight Loss Measurements
The dry weight reduction of the LDPE powder was measured after 180 days of incubation with APCK5 and APCZ14 (Table 3). A substantial decrease in the LDPE weight was observed at 8.1 ± 0.63% and 18.85 ± 0.96% for APCK5 and APCZ14, respectively. A slight change in the dry weight of the untreated control powder was observed (1.7 ± 0.2%, Table 3).
3.2.3. Structural Changes of Polyethylene by Fourier Transform Infrared (FTIR) Analysis
When comparing treated LDPE to control samples, FTIR revealed both the chemical change and the appearance of a new peak (Figure 3). Figure 3 showed a remarkable increase in the intensity of the peak corresponding to C-H mono-bending (1715 cm−1), C-C stretching (1461 cm−1), C-H stretching symmetrically (2847 cm−1), and C-H stretching symmetrically (2914 cm−1) in the LDPE powder after 180 days of incubation with APCK5 and APCZ14.

Figure 3.
FTIR spectra of LDPE powder after incubation for 180 days with APCK5, APCZ14, and control.
Furthermore, LDPE treated with APCK5 and APCZ14 showed new peaks in the range of (a) 1650 cm−1 corresponding to the formation of double bonds; (b) cm−1 corresponding to the formation of acids; and (c) 1740 cm−1 corresponding to the formation of ketone (Figure 4).

Figure 4.
FTIR spectra of LDPE powder after 180-day incubation with APCK5, APCZ14 and control. (a) double bonds (1640 cm−1), (b) acids (1715 cm−1), and (c) ketones (1740 cm−1).
3.2.4. GS–MS Analysis
A wide range of substances, such as volatile and semi-volatile alkanes, aromatic hydrocarbons, esters, saturated fatty acids, and unsaturated fatty acids, were identified in the LDPE-treated and untreated samples using GC–MS analysis (Figure 5 and Figure 6). Additionally, a number of unidentified compounds were obtained. The analysis revealed the media treated with APCK5 had 42 compounds, while the media treated with APCZ14 had 54 compounds; 30 of these compounds were present in both treatments. The analysis revealed 42 and 54 compounds in the media treated with APCK5 and APCZ14, respectively, 30 compounds of which existed in both treatments. There were 30 similar compounds out of 54, whereas three of the compounds were unidentified in PACK5, as well as 20 compounds in APCZ14. Three and 20 unidentified compounds were reported in the APCK5 and APCZ14, respectively. However, 39 compounds were identified in the control sample, two of which had unknown chemical structures. As for the control (Figure 5a), 36 were found that were similar to APCK5, as were 31 similar to APCZ14.

Figure 5.
GC–MS of LDPE degradation products: (a) control, (b) APCK5, and (c) APCZ14.

Figure 6.
GC–MS for the highest compounds; heneicosane, 2,4-di-tert-butylphenol, and butylated hydroxytoluene after 180-day incubation with APCK5, APCZ14, and control.
4. Discussion
The purpose of this study was to identify and characterize LDPE plastic degrading bacteria from the Al-Ahsa region of Saudi Arabia using synthetic media (SM) supplemented with LDPE powder as the sole carbon source. Two bacterial isolates (APCK5 and APCZ14) were obtained from a water sample at Al-Ahsa Plastic Products Company. Both isolates exhibited potential LDPE degradation, as evidenced by the change in pH values of the media, the reduction of the LDPE weight, and the FTIR and GC–MS analyses. Based on 16S rRNA gene similarities, APCZ14 and APCK5 were determined to be most closely related to the genus Brucella. APCZ14 exhibited a 99.48% homology with Brucella cytisi ESC1 (accession number AY776289), whereas APCK5 showed a 99.33% similarity level to Brucella tritici SCII24 AJ242584.
It is generally established that the 16S ribosomal RNA gene is a powerful tool for identifying bacteria at the genus and species levels and is utilized for phylogenetic inferences across prokaryotes [51]. It was revealed, on the basis of similarities in their 16S rRNA gene sequences, that APCZ14 and APCK5 are most closely related to the genus Brucella. APCK5 displayed a similarity level of 99.33% to Brucella tritici SCII24 (accession number AY242584), whereas APCZ14 showed a homology of 99.48% with Brucella cytisi ESC1 (accession number AY776289). Similarly, phylogenetic analyses using 16S rRNA gene sequences revealed that the APCZ14 and APCK5 strains were clearly clustered within the Brucella clade, providing a credible identity for the strains APCZ14 and APCK5. These findings provide further evidence for the efficiency of the 16S rRNA for the identification of bacterial species.
The reduction in pH of the SM inoculated with APCK5 and APCZ14 demonstrated that both isolates have the potential to consume LDPE as a carbon source and become metabolically active during incubation. Similar results have been obtained by [52], who showed that the pH of the media containing LDPE was reduced from 7.12 to 6.67 for Ralstonia sp. and from 7.12 to 7.03 for Bacillus sp. after 180 days of incubation. It can be speculated that the biodegradation of LDPE due to the bacterial action (APCK5 and APCZ14) resulted in the secretion of certain intermediates, including acids, which could lower the pH value of the medium. It has been suggested that the reduction in pH indicates the presence of extracellular enzymes and the metabolic activity of the microorganisms to utilize LDPE as a source of carbon. Additionally, the depolymerization and fragmentation of LDPE would lead to the formation of products such as fatty acids and organic acids, which could result in a decrease in pH [53,54].
A large body of evidence indicates that the biodegradability of LDPE is accompanied by a decrease in weight. Several studies have claimed that weight loss is the initial stage of polythene degradation. The finding that showed a significant reduction in LDPE weight at 8.1% and 18.85% due to the activities of APCK5 and APCZ14, respectively, is consistent with previous studies [52]. It has recently been reported that P. aeruginosa V1 showed the most significant degradation of LDPE, with a percentage weight loss of 18.21% [55]. In order to use the carbon and energy contained inside these complex molecules, microorganisms release a variety of enzymes that first break them down into simpler building blocks [56], which are then consumed as carbon sources. Consequently, a weight reduction in the LDPE is generated [40]. The pH and weight decrease confirmed that both isolates could utilize LDPE as their sole carbon source.
Since FTIR is sensitive to the local molecular complexes, it has been widely used to evaluate the interactions between macromolecules during the process of LDPE breakdown. This is because of the sensitivity of FTIR to the local molecular environment [57]. FTIR analysis was used to monitor damage to the quality of the material by many physical and chemical processes and the structural transformation of LDPE, leading to the degradation of the polymer [1]. The structural alterations of the LDPE were assessed using Fourier transform infrared (FTIR) analysis to further monitor the biodegradability via the bacterial isolates APCK5 and APCZ14 [57]. The FTIR is the approach that is used to evaluate the changes in polyethene bonds and chemical composition. When compared with the control, the treated LDPE exhibited a change, as well as a new peak, which was validated by FTIR. LDPE treated with APCK5 and APCZ14 developed new peaks at (a) 1650 cm−1 corresponding to the formation of double bonds; (b) 1715 cm−1 corresponding to the formation of acids; and (c) 1740 cm−1 corresponding to the formation of ketone, suggesting that the formation of chemically distinct intermediates during the biodegradation process. A comparable profile of LDPE spectra was obtained by [58], who found new peaks at 1250.33 cm−1 and 1246.44 cm−1, which correspond to the C–O stretching of esters groups in Methylobacterium radiotolerans and Lysinibacillus fusiformis, respectively [58]. When a hydrogen atom on a long carbon–carbon bond is replaced by an oxygen atom, functional groups such as ester groups, carbonyl groups, and ether groups can be generated [59]. Interestingly, it has been reported that alkane hydroxylases play a pivotal role in aerobic alkane degradation via the formation of primary and secondary alcohols by hydroxylation of carbon–carbon bonds [60]. Furthermore, epoxidation of alkenes by microbial alkene monooxygenase leads to the formation of ether during LDPE biodegradation [61]. Based on these findings, it can be suggested that a change in peak position, the appearance of new peaks, or the disappearance of already existing ones are all indications of structural alterations in LDPE caused by degrading microorganisms.
For further confirmation of LDPE biodegrading, GC–MS was applied.
GC–MS appears to be the most effective technique for identifying volatile degradation products [62]. Dominant products were butylated hydroxytoluene, heneicosane, and 2,4-di-tert-butylphenol (Figure 6). The presence of these compounds proves the decomposition of LDPE; a similar order was reported by [63,64].
In general, similar GC–MS profiles to our study have been reported by [65] for Aspergillus nomius and Streptomyces sp. and by [66] for Bacillus licheniformis SARR1. Nonetheless, the compounds obtained might be the same or unique to the microbial group.
Furthermore, a varying number of biodegraded compounds of polyethylene was obtained due to the action of various microbial groups. For example, six and eight compounds were detected after incubation with Aspergillus nomius and Streptomyces sp., respectively, for 90 days [65]. Based on our and others’ results, one can speculate that the extent of the LDPE degradation varies according to the microbial strain, growth, and degradation conditions. It has recently been reported that a novel bacterial strain Brucella intermedium PDB13 obtained from the earthworm gut displayed a remarkable ability to degrade the eonicotinoid insecticide acetamiprid [67] and that the Brucella melitensis strain J2 selectively degrades the organosulfur compound methyldi-benzothiophenes [68].
It should be noted that the control sample has no pH change, which indicates that there was no microbial activity. On the other hand, there was a slight weight loss and LDPE-degrading compounds were found in the GC–MS analysis, but in lower quantities than in APCK5 and APCZ14, which more likely suggests that there was abiotic degradation in the control sample.
The GC–MS results provided further evidence of LDPE degradation by APCK5 and APCZ14 without any pretreatment. Our results seem to pave the way for further investigation to decipher the exact mechanism by which Brucella cytisi and Brucella tritici degrade LDPE.
5. Conclusions
In this study, we identified two LDPE-degrading bacterial strains (APCK5 and APCZ14) that shared a 99.48% and 99.33% homology with Brucella cytisi and Brucella tritici, respectively. The strains’ ability to break down LDPE plastic was confirmed by a media pH decrease, weight loss, FTIR structural changes, and GC–MS intermediate production. Both strains can be widely used as an environmentally beneficial way to eliminate or reduce LDPE pollutants from the environment. To the best knowledge of the authors, this is the first report addressing LDPE biodegradability through Brucella cytisi and Brucella tritici, suggesting that it may be a more widespread trait than currently thought.
Supplementary Materials
The following are available online at https://www.mdpi.com/article/10.3390/app13074629/s1, Figure S1: FTIR spectrum of LDPE powder biodegradation by APCK5 after 180 days of incubation; Figure S2: FTIR spectrum of LDPE powder biodegradation by APCZ14 after 180 days of incubation; Figure S3: FTIR spectrum of LDPE powder at untreated control sample after 180 days of incubation; Figure S4: GC-MS of LDPE degradation products (a) control, (b) APCK5, and (c) APCZ14.
Author Contributions
N.J.A., methodology, data curation, writing—original draft preparation. M.F.A., conceptualization, supervision, project administration, funding acquisition. A.K., methodology, supervision, writing—original draft preparation, writing—review and editing. All authors have read and agreed to the published version of the manuscript.
Funding
This work was supported by the Deanship for Research and Innovation, Ministry of Education in Saudi Arabia for funding this research work through the project number INST165.
Data Availability Statement
Supplementary data are submitted with the manuscript.
Acknowledgments
The authors extend their appreciation to the Deanship for Research and Innovation, Ministry of Education in Saudi Arabia for funding this research work through the project number INST165.
Conflicts of Interest
The authors declare no conflict of interest.
References
- Evode, N.; Qamar, S.A.; Bilal, M.; Barceló, D.; Iqbal, H.M. Plastic waste and its management strategies for environmental sustainability. Case Stud. Chem. Environ. Eng. 2021, 4, 100142. [Google Scholar] [CrossRef]
- Nanda, S.; Patra, B.R.; Patel, R.; Bakos, J.; Dalai, A.K. Innovations in applications and prospects of bioplastics and biopolymers: A review. Environ. Chem. Lett. 2022, 20, 379–395. [Google Scholar] [CrossRef] [PubMed]
- Agenda, I. The New Plastics Economy Rethinking the Future of Plastics; World Economic Forum: Colony, Switzerland, 2016. [Google Scholar]
- Ameen, F.; Moslem, M.; Hadi, S.; Al-Sabri, A.E. Biodegradation of Low Density Polyethylene (LDPE) by Mangrove fungi from the red sea coast. Prog. Rubber Plast. Recycl. Technol. 2015, 31, 125–143. [Google Scholar] [CrossRef]
- Plasticseurope. Plastics the Facts 2020. Available online: https://plasticseurope.org/de/wissenshub/ (accessed on 12 January 2023).
- Mordor Intelligence. Saudi Arabia Plastic Packaging Market-Growth, Trends, COVID-19 Impact, and Forecasts (2021–2026). Available online: https://www.mordorintelligence.com/industry-reports/saudi-arabia-rigid-plastic-packaging-market (accessed on 12 January 2023).
- Research and Markets Businesswire. Saudi Arabia Plastic Packaging Market Growth, Trends, and Forecast Report 2019–2024. Available online: https://eds-p-ebscohost-com.sdl.idm.oclc.org/eds/detail/detail?vid=11&sid=2b97b23e-ea9b-4078-9299-3c0ea90ef7b8%40redis&bdata=JnNpdGU9ZWRzLWxpdmU%3d#db=rps&AN=bizwire.bw95501727 (accessed on 12 January 2023).
- Soud, S.A. Biodegradation of Polyethylene LDPE plastic waste using Locally Isolated Streptomyces sp. J. Pharm. Sci. Res. 2019, 11, 1333–1339. [Google Scholar]
- Gulf Petrochemicals & Chemicals Association (GPCA). A New Horizon for the Gcc Plastic Processing Industry. Available online: https://gpca.org.ae/wp-content/uploads/2018/07/A-New-Horizon-for-the-GCC-Plastic-Processing-Industry.pdf (accessed on 18 January 2023).
- Dey, S.; Tribedi, P. Microbial functional diversity plays an important role in the degradation of polyhydroxybutyrate (PHB) in soil. 3 Biotech 2018, 8, 1–8. [Google Scholar] [CrossRef]
- Dun, M.; Fu, H.; Hao, J.; Shan, W.; Wang, W. Tailoring flexible interphases in bamboo fiber-reinforced linear low-density polyethylene composites. Compos. Part A Appl. Sci. Manuf. 2021, 150, 106606. [Google Scholar] [CrossRef]
- Isangedighi, I.A.; David, G.S.; Obot, O.I. Plastic waste in the aquatic environment: Impacts and management. In Analysis of Nanoplastics and Microplastics in Food; CRC Press: Boca Raton, FL, USA, 2020; pp. 15–43. [Google Scholar]
- Tang, K.H.D. Interactions of microplastics with persistent organic pollutants and the ecotoxicological effects: A review. Trop. Aquat. Soil Pollut. 2021, 1, 24–34. [Google Scholar] [CrossRef]
- Andrady, A.L. The plastic in microplastics: A review. Mar. Pollut. Bull. 2017, 119, 12–22. [Google Scholar] [CrossRef]
- Alshehrei, F. Biodegradation of synthetic and natural plastic by microorganisms. J. Appl. Environ. Microbiol. 2017, 5, 8–19. [Google Scholar]
- Iram, D.; Riaz, R.; Iqbal, R.K. Usage of potential micro-organisms for degradation of plastics. Open J. Environ. Biol. 2019, 4, 7–15. [Google Scholar]
- Kensa, V.M. Bioremediation-an overview. J. Ind. Pollut. Control. 2011, 27, 161–168. [Google Scholar]
- Pathak, V.M. Review on the current status of polymer degradation: A microbial approach. Bioresour. Bioprocess. 2017, 4, 1–31. [Google Scholar] [CrossRef]
- Ogunbayo, A.; Olanipekun, O.; Adamu, I. Preliminary studies on the microbial degradation of plastic waste using Aspergillus niger and Pseudomonas sp. J. Environ. Prot. 2019, 10, 625–631. [Google Scholar] [CrossRef]
- El-Sayed, M.T.; Rabie, G.H.; Hamed, E.A. Biodegradation of low-density polyethylene (LDPE) using the mixed culture of Aspergillus carbonarius and A. fumigates. Environ. Dev. Sustain. 2021, 23, 14556–14584. [Google Scholar] [CrossRef]
- Joshi, G.; Goswami, P.; Verma, P.; Prakash, G.; Simon, P.; Vinithkumar, N.V.; Dharani, G. Unraveling the plastic degradation potentials of the plastisphere-associated marine bacterial consortium as a key player for the low-density polyethylene degradation. J. Hazard. Mater. 2022, 425, 128005. [Google Scholar] [CrossRef] [PubMed]
- Ruslan, R.; Pekey, A.; Iqbal, M. Characterization of Bacillus sp. ITP 10.2. 1 as degrading-bacteria of polyethylene terephthalate (PET) synthetic plastic. Int. J. Pharm. 2018, 9, 56–59. [Google Scholar]
- Miloloža, M.; Ukić, Š.; Cvetnić, M.; Bolanča, T.; Kučić Grgić, D. Optimization of Polystyrene Biodegradation by Bacillus cereus and Pseudomonas alcaligenes Using Full Factorial Design. Polymers 2022, 14, 4299. [Google Scholar] [CrossRef] [PubMed]
- Zadjelovic, V.; Erni-Cassola, G.; Obrador-Viel, T.; Lester, D.; Eley, Y.; Gibson, M.I.; Dorador, C.; Golyshin, P.N.; Black, S.; Wellington, E.M. A mechanistic understanding of polyethylene biodegradation by the marine bacterium Alcanivorax. J. Hazard. Mater. 2022, 436, 129278. [Google Scholar] [CrossRef]
- Saeed, S.; Iqbal, A.; Deeba, F. Biodegradation study of Polyethylene and PVC using naturally occurring plastic degrading microbes. Arch. Microbiol. 2022, 204, 497. [Google Scholar] [CrossRef]
- Wu, X.; Liu, P.; Zhao, X.; Wang, J.; Teng, M.; Gao, S. Critical effect of biodegradation on long-term microplastic weathering in sediment environments: A systematic review. J. Hazard. Mater. 2022, 437, 129287. [Google Scholar] [CrossRef]
- Elsamahy, T.; Sun, J.; Elsilk, S.E.; Ali, S.S. Biodegradation of low-density polyethylene plastic waste by a constructed tri-culture yeast consortium from wood-feeding termite: Degradation mechanism and pathway. J. Hazard. Mater. 2023, 448, 130944. [Google Scholar] [CrossRef] [PubMed]
- Ndahebwa Muhonja, C.; Magoma, G.; Imbuga, M.; Makonde, H.M. Molecular characterization of low-density polyethene (LDPE) degrading bacteria and fungi from Dandora dumpsite, Nairobi, Kenya. Int. J. Microbiol. 2018, 2018, 1–10. [Google Scholar] [CrossRef] [PubMed]
- Zhang, Y.; Lin, Y.; Gou, H.; Feng, X.; Zhang, X.; Yang, L. Screening of polyethylene-degrading bacteria from rhyzopertha dominica and evaluation of its key enzymes degrading polyethylene. Polymers 2022, 14, 5127. [Google Scholar] [CrossRef] [PubMed]
- Bher, A.; Mayekar, P.C.; Auras, R.A.; Schvezov, C.E. Biodegradation of Biodegradable Polymers in Mesophilic Aerobic Environments. Int. J. Mol. Sci. 2022, 23, 12165. [Google Scholar] [CrossRef]
- Dey, U.; Mondal, N.K.; Das, K.; Dutta, S. An approach to polymer degradation through microbes. IOSR J. Pharm. 2012, 2, 385–388. [Google Scholar]
- Wilkes, R.-A.; Aristilde, L. Degradation and metabolism of synthetic plastics and associated products by Pseudomonas sp.: Capabilities and challenges. J. Appl. Microbiol. 2017, 123, 582–593. [Google Scholar] [CrossRef]
- Oyehan, T.A.; Al-Thukair, A.A. Isolation and characterization of PAH-degrading bacteria from the Eastern Province, Saudi Arabia. Mar. Pollut. Bull. 2017, 115, 39–46. [Google Scholar] [CrossRef]
- Muhonja, C.N.; Makonde, H.; Magoma, G.; Imbuga, M. Biodegradability of polyethylene by bacteria and fungi from Dandora dumpsite Nairobi-Kenya. PLoS ONE 2018, 13, e0198446. [Google Scholar] [CrossRef]
- Begum, M.A.; Varalakshmi, B.; Umamagheswari, K. Biodegradation of polythene bag using bacteria isolated from soil. Int. J. Curr. Microbiol. App. Sci. 2015, 4, 674–680. [Google Scholar]
- Lee, J.-G.; Cheong, K.H.; Huh, N.; Kim, S.; Choi, J.-W.; Ko, C. Microchip-based one step DNA extraction and real-time PCR in one chamber for rapid pathogen identification. Lab Chip 2006, 6, 886–895. [Google Scholar] [CrossRef]
- Hu, M.; Zhang, F.; Li, G.; Ruan, H.; Li, X.; Zhong, L.; Chen, G.; Rui, Y. Falsochrobactrum tianjinense sp. nov., a New Petroleum-Degrading Bacteria Isolated from Oily Soils. Int. J. Environ. Res. Public Health 2022, 19, 11833. [Google Scholar] [CrossRef] [PubMed]
- Yadav, S.; Kaushik, R.; Saxena, A.K.; Arora, D.K. Diversity and phylogeny of plant growth-promoting bacilli from moderately acidic soil. J. Basic Microbiol. 2011, 51, 98–106. [Google Scholar] [CrossRef] [PubMed]
- Sriyapai, P.; Chansiri, K.; Sriyapai, T. Isolation and characterization of polyester-based plastics-degrading bacteria from compost soils. Microbiology 2018, 87, 290–300. [Google Scholar] [CrossRef]
- Das, M.P.; Kumar, S. An approach to low-density polyethylene biodegradation by Bacillus amyloliquefaciens. 3 Biotech 2015, 5, 81–86. [Google Scholar] [CrossRef]
- Harshvardhan, K.; Jha, B. Biodegradation of low-density polyethylene by marine bacteria from pelagic waters, Arabian Sea, India. Mar. Pollut. Bull. 2013, 77, 100–106. [Google Scholar] [CrossRef]
- Ruslan, R.; Iqbal, M.; Pekey, A.; Dewi, A.; Djamaan, A. Isolation and characterization of polystyrene-degrading bacteria Bacillus sp. ITP 10.1. 1 from soil sample of Jayawijaya Mountains, Papua, Indonesia. Int. Res. J. Pharm. 2018, 9, 85–88. [Google Scholar] [CrossRef]
- Deepika, S.; Jaya, M. Biodegradation of low density polyethylene by microorganisms from garbage soil. J. Exp. Biol. Agric. Sci. 2015, 3, 1–5. [Google Scholar]
- Pramila, R.; Ramesh, K.V. Biodegradation of low density polyethylene (LDPE) by fungi isolated from marine water a SEM analysis. Afr. J. Microbiol. Res. 2011, 5, 5013–5018. [Google Scholar] [CrossRef]
- Shahnawaz, M.; Sangale, M.K.; Ade, A.B. Bacteria-based polythene degradation products: GC-MS analysis and toxicity testing. Environ. Sci. Pollut. Res. 2016, 23, 10733–10741. [Google Scholar] [CrossRef]
- Adam, M. Biodegradation of marine crude oil pollution using a salt-tolerant bacterial consortium isolated from Bohai Bay, China. Mar. Pollut. Bull. 2016, 105, 43–50. [Google Scholar]
- El Sherif, F.; Albotnoor, N.; Yap, Y.-K.; Meligy, A.; Khattab, S. Enhanced bioactive compounds composition in Lavandula officinalis in-vitro plantlets using NaCl and Moringa oleifera, Aloe vera and Spirulina platensis extracts. Ind. Crops Prod. 2020, 157, 112890. [Google Scholar] [CrossRef]
- Saitou, N.; Nei, M. The neighbor-joining method: A new method for reconstructing phylogenetic trees. Mol. Biol. Evol. 1987, 4, 406–425. [Google Scholar] [PubMed]
- Tamura, K.; Nei, M.; Kumar, S. Prospects for inferring very large phylogenies by using the neighbor-joining method. Proc. Natl. Acad. Sci. USA 2004, 101, 11030–11035. [Google Scholar] [CrossRef] [PubMed]
- Kumar, S.; Stecher, G.; Tamura, K. MEGA7: Molecular evolutionary genetics analysis version 7.0 for bigger datasets. Mol. Biol. Evol. 2016, 33, 1870–1874. [Google Scholar] [CrossRef]
- Faniyan, O.; Akpe, V.; Cock, I.E. Analyzing Bacterial Species from Different Environments Using Direct 16S rRNA Gene Sequencing Methods. Pharmacogn. Commun. 2023, 13, 24–33. [Google Scholar] [CrossRef]
- Biki, S.P.; Mahmud, S.; Akhter, S.; Rahman, M.J.; Rix, J.J.; Al Bachchu, M.A.; Ahmed, M. Polyethylene degradation by Ralstonia sp. strain SKM2 and Bacillus sp. strain SM1 isolated from land fill soil site. Environ. Technol. Innov. 2021, 22, 101495. [Google Scholar] [CrossRef]
- Ojha, N.; Pradhan, N.; Singh, S.; Barla, A.; Shrivastava, A.; Khatua, P.; Rai, V.; Bose, S. Evaluation of HDPE and LDPE degradation by fungus, implemented by statistical optimization. Sci. Rep. 2017, 7, 1–13. [Google Scholar] [CrossRef]
- Awasthi, S.; Srivastava, N.; Singh, T.; Tiwary, D.; Mishra, P.K. Biodegradation of thermally treated low density polyethylene by fungus Rhizopus oryzae NS 5. 3 Biotech 2017, 7, 1–8. [Google Scholar] [CrossRef]
- Pathak, V.M. Exploitation of bacterial strains for microplastics (LDPE) biodegradation. Chemosphere 2023, 137845. [Google Scholar] [CrossRef]
- Singh, G.; Singh, A.K.; Bhatt, K. Biodegradation of polythenes by bacteria isolated from soil. Int. J. Res. Dev. Pharm. Life Sci. 2016, 5, 2056–2062. [Google Scholar]
- Gajendiran, A.; Krishnamoorthy, S.; Abraham, J. Microbial degradation of low-density polyethylene (LDPE) by Aspergillus clavatus strain JASK1 isolated from landfill soil. 3 Biotech 2016, 6, 1–6. [Google Scholar] [CrossRef] [PubMed]
- Nademo, Z.M.; Shibeshi, N.T.; Gemeda, M.T. Isolation and screening of low-density polyethylene (LDPE) bags degrading bacteria from Addis Ababa municipal solid waste disposal site “Koshe”. Ann. Microbiol. 2023, 73, 1–11. [Google Scholar] [CrossRef]
- Ren, L.; Men, L.; Zhang, Z.; Guan, F.; Tian, J.; Wang, B.; Wang, J.; Zhang, Y.; Zhang, W. Biodegradation of polyethylene by Enterobacter sp. D1 from the guts of wax moth Galleria mellonella. Int. J. Environ. Res. Public Health 2019, 16, 1941. [Google Scholar] [CrossRef] [PubMed]
- Mohanan, N.; Montazer, Z.; Sharma, P.K.; Levin, D.B. Microbial and enzymatic degradation of synthetic plastics. Front. Microbiol. 2020, 11, 580709. [Google Scholar] [CrossRef] [PubMed]
- Zhang, N.; Ding, M.; Yuan, Y. Current advances in biodegradation of polyolefins. Microorganisms 2022, 10, 1537. [Google Scholar] [CrossRef]
- Xu, L.; Wang, S.; Tian, A.; Liu, T.; Benjakul, S.; Xiao, G.; Ying, X.; Zhang, Y.; Ma, L. Characteristic volatile compounds, fatty acids and minor bioactive components in oils from green plum seed by HS-GC-IMS, GC–MS and HPLC. Food Chem. X 2023, 17, 100530. [Google Scholar] [CrossRef]
- Sarker, M.; Rashid, M.M.; Rahman, M.S. Low density polyethylene (LDPE) waste plastic transformation into renewable heavy fuel using thermal cracking. World Environ. 2012, 2, 140–147. [Google Scholar] [CrossRef]
- Garcia Ibarra, V.; Sendón, R.; García-Fonte, X.X.; Paseiro Losada, P.; Rodríguez Bernaldo de Quirós, A. Migration studies of butylated hydroxytoluene, tributyl acetylcitrate and dibutyl phthalate into food simulants. J. Sci. Food Agric. 2019, 99, 1586–1595. [Google Scholar] [CrossRef]
- Abraham, J.; Ghosh, E.; Mukherjee, P.; Gajendiran, A. Microbial degradation of low density polyethylene. Environ. Prog. Sustain. Energy 2017, 36, 147–154. [Google Scholar] [CrossRef]
- Rani, R.; Rathee, J.; Kumari, P.; Singh, N.P.; Santal, A.R. Biodegradation and detoxification of low-density polyethylene by an indigenous strain Bacillus licheniformis SARR1. J. Appl. Biol. Biotechnol. 2022, 10, 9–21. [Google Scholar]
- Elango, D.; Siddharthan, N.; Alaqeel, S.I.; Subash, V.; Manikandan, V.; Almansour, A.I.; Kayalvizhi, N.; Jayanthi, P. Biodegradation of neonicotinoid insecticide acetamiprid by earthworm gut bacteria Brucella intermedium PDB13 and its ecotoxicity. Microbiol. Res. 2023, 268, 127278. [Google Scholar] [CrossRef] [PubMed]
- Wang, X.; Cai, T.; Wen, W.; Ai, J.; Ai, J.; Zhang, Z.; Zhu, L.; George, S.C. Surfactin for enhanced removal of aromatic hydrocarbons during biodegradation of crude oil. Fuel 2020, 267, 117272. [Google Scholar] [CrossRef]
Disclaimer/Publisher’s Note: The statements, opinions and data contained in all publications are solely those of the individual author(s) and contributor(s) and not of MDPI and/or the editor(s). MDPI and/or the editor(s) disclaim responsibility for any injury to people or property resulting from any ideas, methods, instructions or products referred to in the content. |
© 2023 by the authors. Licensee MDPI, Basel, Switzerland. This article is an open access article distributed under the terms and conditions of the Creative Commons Attribution (CC BY) license (https://creativecommons.org/licenses/by/4.0/).